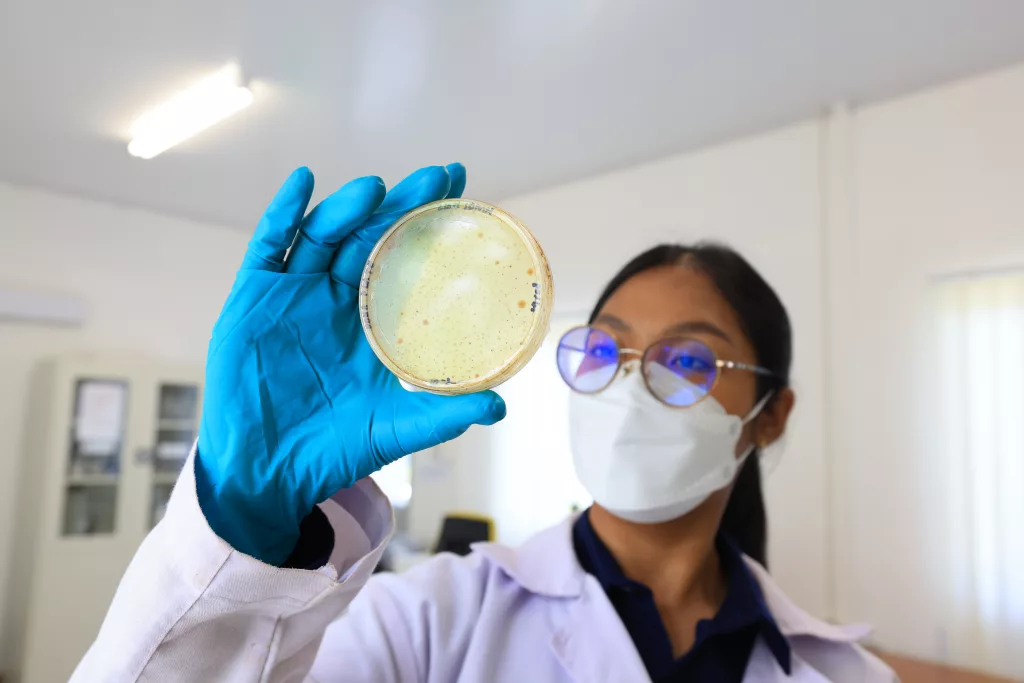

Beneath the seemingly still soil lies a world of life working in silence. One such presence is mycorrhiza, a soil-dwelling fungus that forms a close association with plant roots in a symbiotic mutualism—a relationship in which both organisms benefit.
Mycorrhiza attaches itself to plant roots and enhances the plant’s ability to absorb water and essential nutrients from the soil. In return, the plant supplies carbohydrates produced through photosynthesis as a source of energy for the fungus. This relationship creates a system of mutual dependence and reinforcement.
The role of mycorrhiza extends beyond a single plant. Through a network of fine thread-like structures known as hyphae, it expands the reach of roots into soil spaces that would otherwise be inaccessible. This network also enables the exchange of nutrients and chemical signals between plants, forming a natural communication system beneath the ground.
Read Also: The Use of Mycorrhiza Improves Reclamation Quality in the Martabe Gold Mine Area
In general, mycorrhiza can be classified into two main types. The first is ectomycorrhiza, which forms a sheath around the surface of plant roots. The second is arbuscular mycorrhiza, also known as endomycorrhiza, which penetrates root tissues and is commonly found in tropical regions, particularly in degraded land.

In the context of mining, post-mining land typically experiences a decline in quality, including low nutrient content, poor soil structure, and limited water retention capacity. These conditions present significant challenges for land rehabilitation and revegetation.
This is where mycorrhiza plays a vital role as a nature-based solution. Its capabilities help to:
- Improve the uptake of essential nutrients such as phosphorus and nitrogen,
- Enhance plant resilience to drought and extreme environmental conditions,
- Improve soil structure, enabling better retention of water and air, and
- Increase the success rate of plant establishment in rehabilitated areas.
The application of mycorrhiza is commonly carried out through inoculation, which involves introducing mycorrhiza to plant seedlings at the nursery stage. In this way, plants develop a beneficial partnership early in their growth, making them better prepared to adapt once planted in the field. Additionally, mycorrhiza can be applied as a biofertiliser mixed directly into the soil.
Findings from various studies, including those conducted in the Martabe Gold Mine area, indicate that mycorrhiza not only thrives in natural forests but can also establish itself in nutrient-poor reclaimed land. Its presence has been shown to accelerate plant growth and support the restoration of biodiversity. Mycorrhiza may not be visible to the eye, yet its role is profoundly real. It is a silent force that sustains life, a quiet ally that strengthens roots, and an essential part of maintaining ecological balance particularly in restoring life to once-degraded land.







